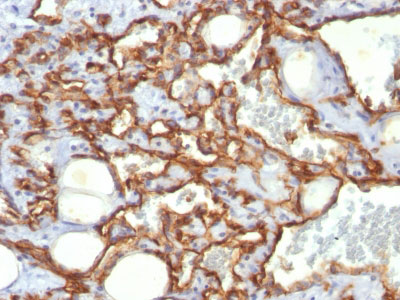

> Antigen, Antibodies, ELISA, Western Blot > Primary Antibody > Monoclonal Antibodies > CD31 / PECAM-1 (Endothelial Cell Marker) Antibody - With BSA and AzideBrand |
Leading Biology | Catalog Number |
AMM00363G |
Product Type |
Monoclonal Antibodies | Field of Research |
|
Product Overview |
We constantly strive to ensure we provide our customers with the best antibodies. As a result of this work we offer this antibody in purified format.
We are in the process of updating our datasheets. If you have any questions regarding this update, please feel free to contact our technical support team.
This product is a high quality CD31 / PECAM-1 (Endothelial Cell Marker) Antibody - With BSA and Azide.
|
||
Molecular Weight |
~100kDa (endothelium) and ~130kDa (platelets)
|
||
Cellular Localization |
Antigen Cellular Localization:
Isoform Long: Cell membrane; Single-pass type I membrane protein. Cell membrane; Lipid-anchor. Cell junction. Note=Localizes to the lateral border recycling compartment (LBRC) and recycles from the LBRC to the junction in resting endothelial cells
|
||
Host |
Mouse
|
||
Species Reactivity |
Human
|
||
Clone |
SPM532
|
||
Isotype |
Mouse / IgG1, kappa
|
||
GeneID |
|||
UniProt ID |
|||
Function |
Induces susceptibility to atherosclerosis (By similarity). Cell adhesion molecule which is required for leukocyte transendothelial migration (TEM) under most inflammatory conditions. Tyr-690 plays a critical role in TEM and is required for efficient trafficking of PECAM1 to and from the lateral border recycling compartment (LBRC) and is also essential for the LBRC membrane to be targeted around migrating leukocytes. Prevents phagocyte ingestion of closely apposed viable cells by transmitting 'detachment' signals, and changes function on apoptosis, promoting tethering of dying cells to phagocytes (the encounter of a viable cell with a phagocyte via the homophilic interaction of PECAM1 on both cell surfaces leads to the viable cell's active repulsion from the phagocyte. During apoptosis, the inside-out signaling of PECAM1 is somehow disabled so that the apoptotic cell does not actively reject the phagocyte anymore. The lack of this repulsion signal together with the interaction of the eat-me signals and their respective receptors causes the attachment of the apoptotic cell to the phagocyte, thus triggering the process of engulfment). Isoform Delta15 is unable to protect against apoptosis. Modulates BDKRB2 activation. Regulates bradykinin- and hyperosmotic shock-induced ERK1/2 activation in human umbilical cord vein cells (HUVEC).
|
||
Summary |
CD31 (PECAM-1) is a transmembrane glycoprotein member of the immunoglobulin supergene family of adhesion molecules. CD31 is expressed by stem cells of the hematopoietic system and is primarily used to identify and concentrate these cells for experimental studies as well as for bone marrow transplantation. Anti-CD31 has shown to be highly specific and sensitive for vascular endothelial cells. Staining of nonvascular tumors (excluding hematopoietic neoplasms) is rare. CD31 MAb reacts with normal, benign, and malignant endothelial cells which make up blood vessel lining. The level of CD31 expression can help to determine the degree of tumor angiogenesis, and a high level of CD31 expression may imply a rapidly growing tumor and potentially a predictor of tumor recurrence.
|
||
Form |
Liquid |
||
Storage & Stability |
Store at +4°C short term. For long-term storage, aliquot and store at -20°C or below. Stable for 12 months at -20°C. Avoid repeated freeze-thaw cycles.
|
||
Applications |
IHC-P, IF, FC
|
||
Images |
Formalin-fixed, paraffin-embedded human Angiosarcoma stained with CD31 Monoclonal Antibody (SPM532) |
||
Specification |
|||
Quantity |
|
||
| Select | Brand | Catalog No. | Product Name | Pack Size | Type | Field of Research | Specification | Quantity | Price(USD) | |
| 1 | Leading Biology | APG02467G | CCK4 / PTK7 Antibody (clone 4F9) | 50 μl | Monoclonal Antibodies |
|
$495.00 | Add Ask | ||
| 2 | Leading Biology | AMM04683G | GALT Antibody (clone 4C11) | 50 μg | Monoclonal Antibodies |
|
$545.00 | Add Ask | ||
| 3 | Leading Biology | AMM01402G | Vimentin (Mesenchymal Cell Marker) Antibody - With BSA and Azide | 50 ug | Monoclonal Antibodies |
|
$395.00 | Add Ask | ||
| 4 | Leading Biology | APR08280G | LTA4H / LTA4 Antibody (clone 9G8) | 50 μl | Monoclonal Antibodies |
|
$495.00 | Add Ask | ||
| 5 | Leading Biology | AMM00172G | CD1a / HTA1 (Mature Langerhans Cells Marker) Antibody - With BSA and Azide | 50 ug | Monoclonal Antibodies |
|
$395.00 | Add Ask | ||
| 6 | Leading Biology | AMM05750G | CEBPA Antibody | 100 μl | Monoclonal Antibodies |
|
$545.00 | Add Ask |
 Leading Biology Inc.
2600 Hilltop DR, Building G, B Suite C138
Richmond, CA, 94806
Tel: 1-661-524(LBI)-0262
Email: info@leadingbiology.com
Leading Biology Inc.
2600 Hilltop DR, Building G, B Suite C138
Richmond, CA, 94806
Tel: 1-661-524(LBI)-0262
Email: info@leadingbiology.com
Complete this form and click send to ask us a question, request a quote or simply say hello.

You have 0 item in your cart

You have 0 item in your inquiry list
